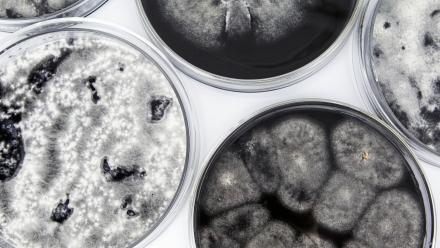

School of Art & Design Seminar Series

The School of Art & Design Seminar Series brings together staff, students, alumni, and friends across the sector to share the latest work in artistic practice, design, and art-historical scholarship in a program of weekly lunchtime talks. All are welcome to join us in the School’s Lecture Theatre or online via Zoom for informal and inspiring conversations covering a diverse range of topics, with a stellar list of speakers from across the ANU campus community and beyond.
The series also provides a public forum for the Sir William Dobell Visiting Chairs and Fellows, generously supported by the Sir William Dobell Art Foundation, hosting leading scholars in art history and related disciplines from across the world.
School of Art & Design Seminar Series runs each Tuesday 1pm - 2pm during semester.
The series is co-convened by Dr Alex Burchmore and Alia Parker.
Past Events
Seminar Series | Susie Russell
“Toward a New Culture”? The Promiscuous Politics and Queer Potential of the ‘Pregnant Man’ PosterIn 1972 a New England Free Press catalogue offered,…
Seminar Series | Dennis Golding
RememberingJoin us for a special lecture as part of the School of Art & Design Seminar Series by Dennis Golding, ANU's 2025 H.C. Coombs Creative…
Seminar Series | Alia Parker
Repairing Repair: patchworking with fungiMyco-remediators are species of fungi that are adept at restoring damaged ecologies and breaking down toxic…